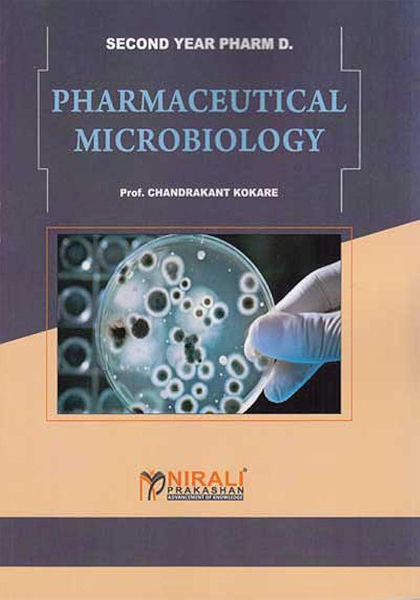

Pharm D Text Books

B Pharm Pages 101 128 Text Version Fliphtml5

Clinpharm India Blog Daily Activity Record For Pharm D

Second Year D Pharm Text Books D Pharm Course Syllabus Rnpd

First Year Diploma In Pharmacy Textbooks Set Of 6 Books Buy First Year Diploma In Pharmacy Textbooks Set Of 6 Books By Nirali At Low Price In India Flipkart Com

Buy A Textbook Of Pharmaceutics First Year Pharm D Book Online At Low Prices In India A Textbook Of Pharmaceutics First Year Pharm D Reviews Ratings Amazon In

Recommended Resources Pharmacy Joe


Inorganic Pharmaceutical Chemistry 1 D Pharm Full Book Pdf Youtube

Teaching Textbooks Review The Happy Housewife Home Schooling

Dipsar Result Out Check Merit List For B Pharm D Pharm M Pharm Here Aglasem Admission
2

Pharm D Complete Notes Books Presentations Expert Mdcat

Buy Text Book Of Pharmacognosy For D Pharma Students At Low Prices In India Pragati Prakashan Educational Publishers

Amazon In Buy A Textbook Of Pharmacology 1 Second Year Pharm D 17 18 Book Online At Low Prices In India A Textbook Of Pharmacology 1 Second Year Pharm D 17 18 Reviews Ratings

A Review Of Indispensable Reflecting Back On How Its Innovative Tools Enhanced My Pharmacy Career

A Textbook Of Pharmacognosy And Phytochemistry I B Pharmacy Semester Iv As Per The Revised 16 17 Regulations Of The Pci Pharmacy Council Of India Latest 19 Edition By Ph D Rajneesh Garg M Pharm

D Pharm Iind Year Pack Of Six Rnpd

Cardiology16 Pdf The Original Book Docsity

Health Education And Comm Pharmacy D Pharm First Year Medical Nursing Books Online S Vikas Gnm Pv Books

Pharmacy For The Curious Pages 1 50 Text Version Anyflip

Pharmaceutical Organic Chemistry 2 Sem B Pharm

Best Pharmacy Books For Gpat Niper Pharmacist And Drug Inspector Exam Preparation Gpatindia Pharmacy Jobs Admissions Scholarships Conference Grants Exam Alerts

Clarification Regarding Remedial Maths And Biology Revolution Pharmd

A Textbook Of Medicinal Chemistry Ii B Pharmacy Semester V As Per The Revised 16 17 Regulations Of The Pci Pharmacy Council Of India Latest 19 Edition By Ph D Dr Ch Narasimharaju Bh M Pharm

Book Set 2 P C I B Pharm Semester 2 Text Books 6 Books Pragati Online

100 Best Pharmacy Books Of All Time Bookauthority

Curriculum School Of Pharmacy

D Pharm Syllabus Course Structure Books Subjects

Books For First Year Pharm D Doctor Of Pharmacy Youtube
Pharm D Books Pdf Free Download Story Of O Book Online

Applied Pharmacology For The Dental Hygienist By Elena Bablenis Haveles Bs Pharm Pharm D Mosby Pharmacology Hygienist Dental Hygienist

Ulektz B Pharm Vi Sem A Textbook Of Pharmaceutical Quality Assurance Pci

Doctor Of Pharmacy Pharmd Notes Pharma Dost

Sia Publishers Pvt Ltd

86 Best Selling Pharmacy Books Of All Time Bookauthority

Amazon In Buy A Textbook Of Pathophysiology Pharm D Ii Year Book Online At Low Prices In India A Textbook Of Pathophysiology Pharm D Ii Year Reviews Ratings

Hospital And Clinical Pharmacy D Pharm Medical Nursing Books Online S Vikas Gnm Pv Books

Textbook Of Pharmaceutics I D Pharm First Year Medical Nursing Books Online S Vikas Gnm Pv Books

Textbook Of Pharmaceutics Ii D Pharm 2nd Year Medical Nursing Books Online S Vikas Gnm Pv Books

A Textbook Of Bio Chemistry For B Pharm D Pharm M Pharm Be B Tech a Mca Me M Tech Diploma B Sc M Sc Competitive Exams Knowledge Seekers By Na Vikraman

Pdf A Text Book Of Human Anatomy Physiology For Pharm D I Year

Dr Craig Svensson Has Published A Book Purdue College Of Pharmacy

Buy Text Book Of Medicinal Chemistry Set Of 2 Vols Book K Ilango P Valentina x Sapnaonline Com India

B Pharm Pages 51 100 Flip Pdf Download Fliphtml5
What Books Should I Buy For Pharm D First Year Quora

Top 15 Pharmacy Textbooks Every Serious Pharmacy Student Should Own

5 Books That All Pharmacists And Aspiring Pharmacists Should Read
3

A Textbook Of Pharmacognosy And Phytochemistry I Pci B Pharmacy Semester Iv Sia Publishers And Distributors P Ltd

Mht Cet B Pharm Preparation Tips Books And Subject Wise Guidance

Pharm D Books Home Facebook

Ccsap 18 Book 2 Toxicology Practice Issues

Aruga S Linkedin

Read Pdf Epub Ebook Book German English Business Correspon

Amazon In Buy A Textbook Of Pharmacognosy And Phytopharmaceuticals Ii Year Pharm D Book Online At Low Prices In India A Textbook Of Pharmacognosy And Phytopharmaceuticals Ii Year Pharm D Reviews Ratings

Pharmaceutical Microbiology With Practicals Pragati Online

A Textbook Of Pharmacology I Pci B Pharmacy Semester Iv Sia Publishers And Distributors P Ltd

Medicinal Chemistry For Pharm D By Illango Valentina By Illango Valentina

Top 15 Pharmacy Textbooks Every Serious Pharmacy Student Should Own
Q Tbn 3aand9gctgf6xhgrjrbsx3cryvrsgu58u2nyjbhrel Vjcydgzslhbdirm Usqp Cau

Text Books And Materials

Amazon In Buy A Textbook Of Pharmaceutical Inorganic Chemistry First Year Pharm D Book Online At Low Prices In India A Textbook Of Pharmaceutical Inorganic Chemistry First Year Pharm D Reviews Ratings

Textbook Of Biochemistry And Clinical Pathology D Pharm Medical Nursing Books Online S Vikas Gnm Pv Books

86 Best Selling Pharmacy Books Of All Time Bookauthority

Read Online Applied Pharmacology For The Dental Hygienist 7e Zkokkuoo

Ncert Books Download Ncert Books And Solutions Pdf
.jpg)
Get The Book Plant Based Pharmacist

Indispensable Gift From Retell Pharmacy Podcast The Happy Pharmd

Ru 19 Pharmd Interview Book By Regis University Issuu

Pdf Geriatric Content In Pharmacotherapy And Therapeutics Textbooks

Pharm D Books Pdf Free Download Story Of O Book Online

Doctor Of Pharmact Pharm D Six Years Osmania University Syllab

Sri Sujatha Law Books Prakasaraopeta Book Shops In Visakhapatnam Justdial

Pharmacology Text Books Lists D Pharm B Pharm Medical Students Top 10 Pharmacology Books

Human Anatomy And Physiology D Pharm Ist Year Medical Nursing Books Online S Vikas Gnm Pv Books
2

Textbook Of Pharmaceutical Chemistry Ii D Pharm Pharmacy Books Nursing Books Paging Publishers

A Textbook Of Bio Chemistry For B Pharm D Pharm M Pharm Be B Tech a Mca Me M Tech Diploma B Sc M Sc Competitive Exams Knowledge Seekers By Na Vikraman

Biostatistics Pharmd Notes Online Pharma Dost

Second Year Diploma In Pharmacy Textbooks Set Of 6 Books Buy Second Year Diploma In Pharmacy Textbooks Set Of 6 Books By Nirali At Low Price In India Flipkart Com

Five Reasons Why People Fail In Pharmacy School

Top 15 Pharmacy Textbooks Every Serious Pharmacy Student Should Own
Http Www Pci Nic In Pdf Pharmd Revised A Pdf

Accp

Emergency Medicine Updates Career Support More Em Pharmd

Pharm D
A Text Book Of Pharmaceutical Microbiology Ebook Ebook Prof Chandrakant Kokare Amazon In Kindle Store

A Text Book Of Organic Chemistry By Bahl And Bahl Pdf Dowload B Pharm 1st Year Books Pdf Dow In Organic Chemistry Books Organic Chemistry Organic Chemistry Study
2

Pharmacist Gift Pharmd Doctor Of Pharmacy Vintage Pharmacy Etsy In Book Page Art Pharmacist Gift Pharmacy Graduation Gift

Dental Pharmacology Books Free Download Pdf Theory Of Computation Book Pdf Free Download

Buy Pharmaceutics For Pharm D Pharmaceutics Text Book Book Online At Low Prices In India Pharmaceutics For Pharm D Pharmaceutics Text Book Reviews Ratings Amazon In

Clinical Research Pharmd Notes Online Pharma Dost
What Books Should I Buy For Pharm D First Year Quora

Essentials Of Pharmacy Management Pharmaceutical Press

Uob Pharm D Its Social Awarness Forum Home Facebook

Buy Pv Pharmaceutical Inorganic Chemistry Sem I B Pharm By Chandrakant P Suryawanshi At Onlinebooksstore In

List Of Best Book To Use In First Year For D Pharm Student On Subscriber Demand Youtube

That Legendary Pharmd Student Who Doctor Of Pharmacy Pharm D Facebook

Optimal Life The Essentials Of Insulin By Christine Lee Pharm D ps Bookshop

Pharmacology Text Books Lists D Pharm B Pharm Medical Students Top 10 Pharmacology Books

Buy Pv A Textbook Of Pharmaceutics I For D Pharm Ist Year Students Book Online At Low Prices In India Pv A Textbook Of Pharmaceutics I For D Pharm Ist Year

Buy Practical Book Of Human Anatomy Physiology For 1st Year B Pharm 1 Sem 1st Year Pharm D Book Deepa S Mandlik Satish K Mandlik 9337 Sapnaonline Com India



